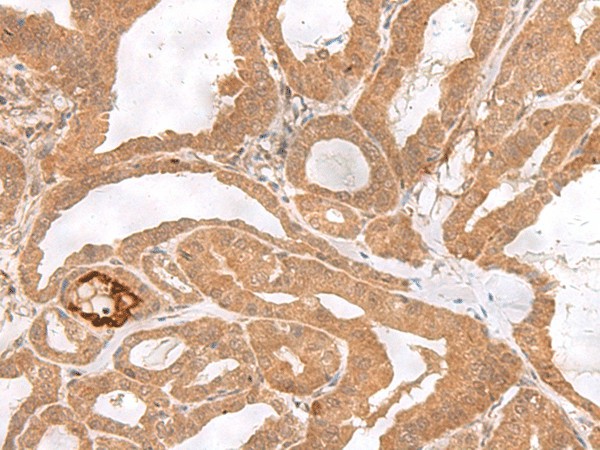
Валидация Elabscience E-AB-17926

| UNIPROT | P41162 |
| Иммуноген | Синтетический пептид, соответствующий человеческому ETV3 |
ETV3 Polyclonal Antibody (E-AB-17926)
Реактивность подтвержденная:
человек, мышь
Источник (хозяин):
кролик
Валидировано для:
IHC
Характеристики
Техническое описание
| Каталожный номер | E-AB-17926 |
| Название антигена | Ets Translocation Variant 3 (ETV3) |
| UNIPROT | P41162 |
| Иммуноген | Синтетический пептид, соответствующий человеческому ETV3 |
| Английские синонимы | PE-1, METS, ETS Family Transcriptional Repressor, ETS domain transcriptional repressor PE1, Mitogenic Ets transcriptional suppressor, ETS variant 3 |
Реактивность подтвержденная Нужна другая реактивность? |
человек, мышь |
| Источник (хозяин) | кролик |
| Изотип | IgG |
| Клональность | поликлональное |
| Рекомбинантное | нет |
| Готовое к использованию | нет |
| Концентрация | 0.72 мг/мл |
| Конъюгат | нет |
| Валидировано для | IHC Иммуногистохимия |
| Рекомендуемые разведения | IHC 1:30-1:150 |
| Метод очистки | Аффинная очистка с антигеном |
| Состав буфера | PBS с 0.05% NaN3 и 40% глицерин,pH7.4 |
| Условия доставки | термобокс с аккумуляторами холода |
| Условия хранения | Хранить при -20°C - 12 месяцев. Избегать повторяющихся циклов замораживания/оттаивания |
| Срок хранения | 12 месяцев |
| Производитель | Elabscience |
| Ссылка на страницу товара на сайте производителя | https://www.elabscience.com/p-etv3_polyclonal_antibody-e_ab_17926 |
Акции и предложения
Популярные продукты:
Human Adenosine diphosphate ELISA kit (E01A0044)
Организм: человек
Диапазон определения: 1-25 нг/мл
Чувствительность: 0.1 нг/мл
Диапазон определения: 1-25 нг/мл
Чувствительность: 0.1 нг/мл
Anti-Human C1q Complement Polyclonal Antibody, FITC (PHD01041)
Источник (хозяин): кролик
Реактивность подтвержденная: человек
Валидировано для: ELISA, IF, WB
Реактивность подтвержденная: человек
Валидировано для: ELISA, IF, WB
ETV3 Polyclonal Antibody (E-AB-17926)
Источник (хозяин): кролик
Реактивность подтвержденная: человек, мышь
Валидировано для: IHC
Реактивность подтвержденная: человек, мышь
Валидировано для: IHC
PE Anti-Mouse CD49d Antibody[R1-2] (AN00422UD)
Источник (хозяин): крыса
Реактивность подтвержденная: человек
Валидировано для: FCM
Реактивность подтвержденная: человек
Валидировано для: FCM
Multiplex Assay Kit for Myogenic Differentiation (MyoD) (LMB692Ra)
Организм: крыса
Диапазон определения: 0.01-10 нг/мл
Чувствительность: 0.003 нг/мл
Диапазон определения: 0.01-10 нг/мл
Чувствительность: 0.003 нг/мл